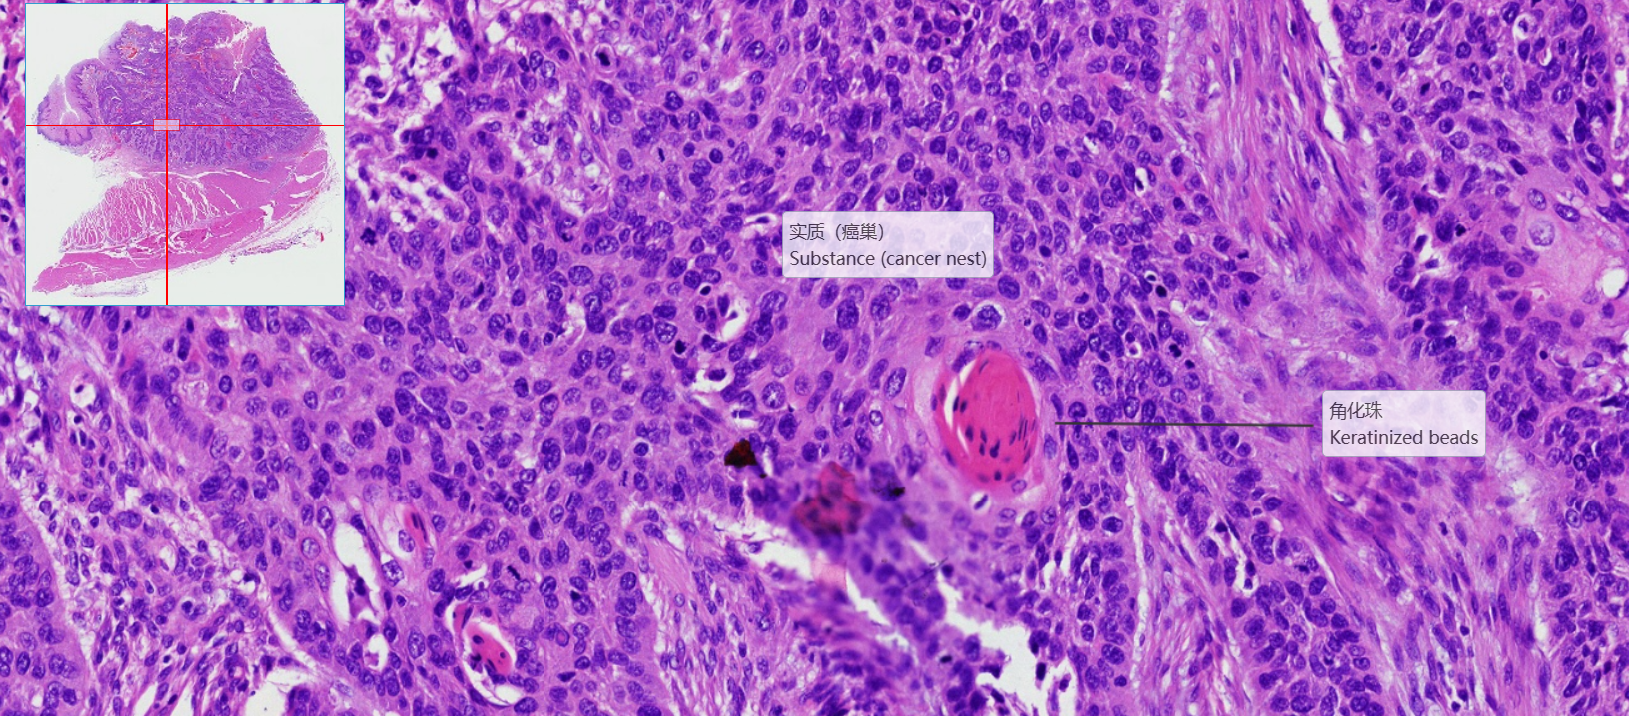
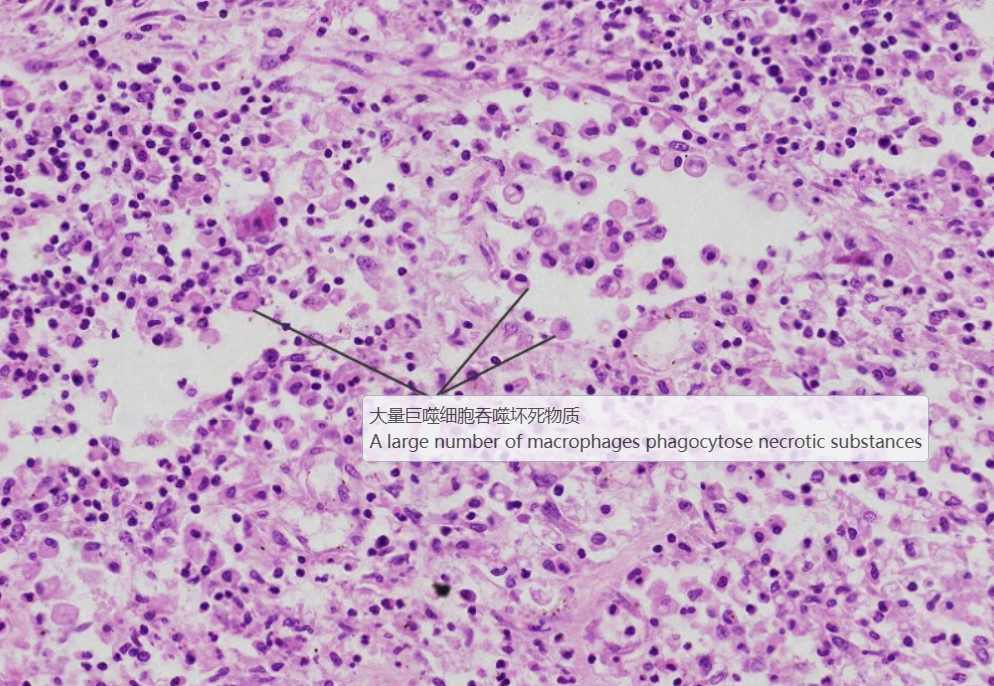

正常-病理对照图
-
1 食管
-
2 胃
-
3 结肠
-
4 食管鳞状细胞癌
-
5 胃溃疡
-
6 溃疡性结肠炎
上一节
下一节
低倍镜观察:观察食管壁四层结构,即黏膜、黏膜下层、肌层和外膜。1、 黏膜:上皮为复层扁平上皮。
固有层突入上皮基底部形成乳头,有些地方因切面关系,乳头似在上皮内。黏膜肌层是一层纵行的平滑肌,
在食管横断面上肌细胞呈横断面。2、 黏膜下层:为疏松结缔组织,呈粉红色,纤维比较粗大,除细胞外,
还有较大的血管。此外,此层可见有黏液性的复管泡状的食管腺。3、 肌层:该片取自食管上三分之一部分,
为骨骼肌。可分为两层,两层之间的结缔组织内有肌间神经丛。
1.全景图

2.管壁四层

3.黏膜层

4.食管腺

5.肌层

6.肌间神经丛







2.结肠腺
3.黏膜下层
4.外膜

4.瘢痕层
5.小动脉管壁增厚


4.巨噬细胞吞噬坏死物